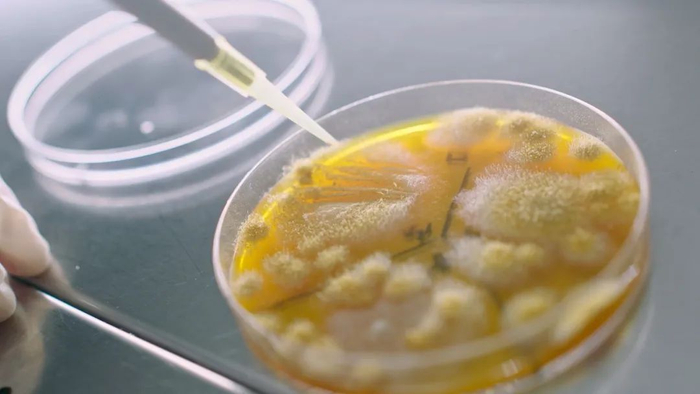
被誉为“核心芯片”的海天菌

99.9%固废回收!近日海天味业公布了2023年ESG发展成果,固体废弃物“近零”排放,实现了99.9%的回收!
2013年,销值成功突破百亿的海天率先于行业喊出了“增产不增污”的目标!时隔10年,这家百年老字号以超高分完成了十年答卷,在产值增长超100%的情况下不仅实现了排放指标有效控制,还超额完成了固体废弃物“近零”排放 。
对于能源需求“大户”的调味品企业来说,这一路并不容易。海天年产量超400万吨,对原料、水、蒸汽、煤炭、玻璃、PET粒子等有着巨大的需求量,从原材料采购、生产研发、生产到包装、运输的每一个环节都可能成为其能否实现“增产不增污”的极致考验。
面对挑战,海天创新性地锁定了“碳足迹管理”,以绿色低碳为量尺,启动了一场全产业链的“绿色革命”。
为产品做“加减法”
实现绿色健康产品全线覆盖
在食品行业,绿色健康是衡量ESG成果的重要指标。曾经,海天的营养健康产品布局并不占优势。近十余年来,海天创新产品策略,依托工艺研发优势扭转“逆风局”,从“后来者”变成了“领跑者”。
依托强大科研实力,借助科学精准过程控制技术,海天不断对产品做“减法”和“加法”,将科研成果转化为高品质绿色健康产品。一方面,通过减糖、减盐、减脂等技术减少产品中的人工添加成分,让产品越来越绿色有机;另一方面,通过增加铁等人体所需的营养成分,让消费者在日常膳食中提升健康素质。目前,海天已推出有机、低糖或减糖、低盐或减盐、低脂或减脂、营养强化等健康趋势产品共计200余款,实现营养健康产品线全面覆盖。

海天绿色健康趋势产品
除了对产品中的营养成分“做加法”,海天还为产品绿色保障“做加法”。其有机系列产品全部通过国家有机产品认证,每瓶产品都有独一无二的“身份证”,可确保全链路的有机可追溯。事实上,海天对有机产品的布局早在2010年已经开始,发展至今已形成有机酱油、有机蚝油、有机调味酱、有机料酒、有机醋等丰富且富有竞争力的产品线,其中有机黄豆酱已取得中国、欧盟、美国三重有机认证。
对调味品而言,“做减法”并不难。难的是,如何减盐却增鲜、无糖却留甜,减少产品中的人工添加成分同时确保产品的不减鲜、不减味。数十年如一日的工艺研发,让海天在产品更加有机绿色但风味不减之间寻到了最优解,这也让消费者感受到了真正的“健康好吃但不贵”。
不得不提的是,海天面向麸质敏感人群的产品“减法”,帮助桥本人群真正实现了“美味无负担”。据了解,海天的研发灵感来源于客户服务热线的一通电话。在充分了解消费者诉求和桥本人群现状后,海天通过一年多的技术研发,将原材料小麦换成了更低敏的大米,“精减”配料表,推出了无麸质酱油,并通过全球标准认证,为特殊人群通过膳食改善身体健康状况持续“加分”。
“99.9%固废回收”背后的
海天“碳足迹管理”
产品碳足迹,是衡量产品对环境影响的量化指标,也是老字号海天践行“增产不增污”和实现绿色可持续发展的标尺。
记者获悉,为了减少产品碳足迹,海天已实施包括工艺改进、优化能源结构及物流管理、采用环保材料、减少包装体积和提升产品耐用性等多项措施,并显著减少碳排放和提升能源使用效率。
其中,近70年的持续菌种研究,为老字号海天的产品碳足迹管理提供了强大的工艺保障。“海天菌”不仅支撑了大规模生产的稳定产品品质,也极大提高了黄豆原材料的转化效率。以酱油菌种每提升1%的利用率计算,每年可节省黄豆约4000多吨。菌种工艺从原材料端实现大幅减排,推动了生态农业绿色可持续发展。
被誉为“核心芯片”的海天菌

海天菌种研发人员
“生产过程中实现固体废弃物‘近零’排放,回收利用率达99.9%。”海天设备负责人表示,数千万的技术设备投入,和“资源循环再造”模式的启用,有效提升了海天的节能减排成果。以节水项目为例,通过对生产基地的冷却水回收利用、减排废水、节约CIP清洗用水等系列管理措施实现了废水回收率达89%,持续降低用水单耗,达同行领先水平。2023年,分别荣获广东“省节水标杆企业”和江苏“省级节水型企业”。
在应对能源危机方面,海天通过扩大光伏发电规模、原料和包装减碳、AI节电技术、锅炉节能改造、余热回收、渣料回收等措施,实现经济效益和环境效益双赢。2021年至2023年期间,海天通过光伏发电减碳排量的年复合增长率达111%(按照0.5703kg/kwh折算);沼气回收利用的年复合增长率达25%。
海天擅长以“小包装”撬动“大减排”。通过“大规格”换“小包装”,全年减少了超18万个纸箱和8万个小包装袋的使用;2023年通过3款玻璃瓶轻量化,减少玻璃用量7000吨。
从企业绿色转型
到全产业链的绿色革命
海天深知供应链减碳的重要性,因此除了自我规范,还持续优化供应链的“碳足迹管理”。
在海天,“节能减排成果”是供应商的基础门槛,即使成功入选的供应商也需要经过海天专门的环保节能意识和技能的专项培训。在产业链的管理上,海天要求确保供应链的环保可追溯。
据悉,海天的生产基地不仅有“厂中厂”的供应商,也有“贴厂”的供应商。很早以前,海天就已开始通过这些创新合作模式,消除中间的包装运输环节减少碳排放。以PET瓶供应商驻场连线供应的模式为例,可减少物料运送车次超5万次,仅去年减少包装耗材用量800 吨;与纸箱厂“贴厂专供”,去年缩短物流运输距离168,000公里。

海天数字化立体仓库
为减少一次性包装,海天与供应商“箱箱共用”、优化原材料包装规格,2023年有效节约超1万个吨桶,减少约87%的原材料包装物使用,实现超99%的包材回收率。海天鼓励供应商提高包装物利用率,全年产品包装回收2200万个。此外,海天还联合供应商进行模具升级和工艺优化,实现全年节省电耗超270万度。
在企业内部推行“无纸化办公”的同时,海天也不忘在供应链端推动了包材COA、采购合同、绩效、收货数量确认单及对账单等电子化项目,大大减少纸张的使用。
多年来,海天坚持在技术创新上和产品有机绿色健康程度上不断做“加法”;在碳排放、废弃物排放等方面不断做“减法”。海天巧用“加减法”,用“碳足迹管理”不断刷新企业绿色透明度,掀起了全行业和全产业链的“绿色革命”!


